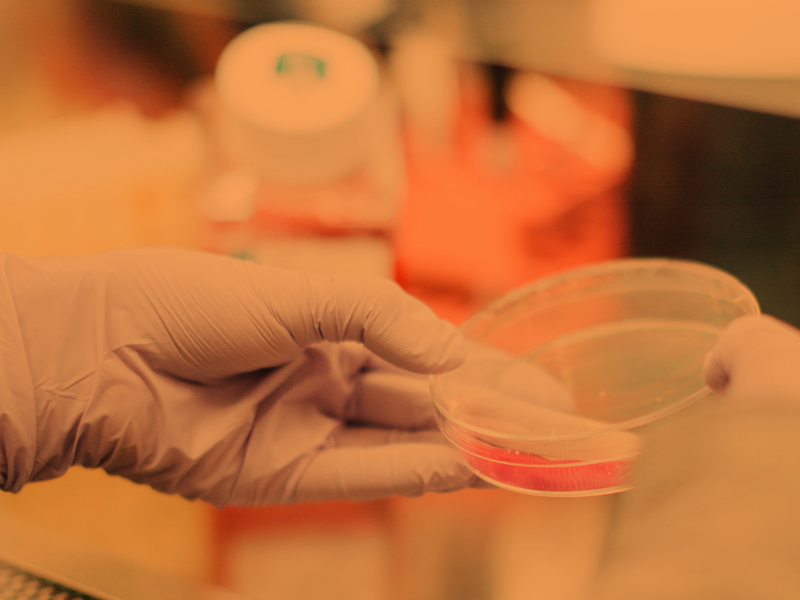

par Marc | Juil 1, 2025 | Conference
A multidisciplinary observational data platform The ARSIA Project is a structured initiative led by ARSIA to implement a multidisciplinary longitudinal observational study on regenerative surgery. The ARSIA Project is a structured initiative led by ARSIA to implement...

par Marc | Juin 24, 2025 | Conference
ARSIA at V-Italy 2025 – Rome, September 3–6 We’re proud to announce our participation in the V-Italy Congress, the international meeting of vascular, regenerative and aesthetic innovation. V-ITALY 2025 – International Congress September 3–6, 2025 · Rome, Italy ARSIA...

par Marc | Juin 24, 2025 | Conference, Topics - Cellular Regeneration, Topics - Tissue Engineering
The Actual Regenerative Surgery International Academy (ARSIA) | official launch replay an initiative led by the Biobridge Foundation with the support of the Académie Nationale de Chirurgie. Watch replay Official Launch Event of ARSIA On May 23, ARSIA (Alliance for...